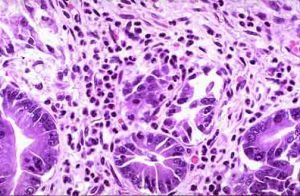
消化病學

人體消化系統
人體消化系統消化系統的結構功能特點與疾病的關係
由於消化道直接開口於體外,接納體外的各種物質,其黏膜接觸病原體、致癌物質、毒性物質的機會較多,在免疫及其他防禦功能減弱的情況下,容易發生感染、炎症、損傷。消化系統腫瘤的發病率較高也可能與此有關。胃癌、食管癌、肝癌、結腸癌、胰腺癌均是常見的惡性腫瘤,在全身惡性腫瘤中占很大的比例。胃腸道與肝臟含有大量單核巨噬細胞,構成消化道的免疫保護屏障,保護胃腸道不愛外來致病因子的侵襲,當這種功能愛損時即出現相應的疾病。胃腸道微生態環境的正常對維持人的健康狀況、抵禦外來微生物的侵害、防止疾病的發生具有重要的意義。分類
消化系統包含的器官很多。本系統疾病的病因也十分複雜,一般有感染、外傷、物理化學因素、中樞神經系統功能失調、營養缺乏、代謝紊亂、吸收障礙、腫瘤、自身免疫、變態反應、先天畸形、遺傳和醫源性因素等。
消化系統疾病有多種分類方法,下面按病變器官分類,並列出各類疾病的主要臨床表現和常見病種:
(一)食管疾病:主要症狀為咽下困難、胸骨後燒灼感、食管反流。常見病種有食管炎、食管癌、食管潰瘍、食管賁門失弛緩症。
急性胃炎的病理表現
急性胃炎的病理表現(三)小腸疾病:主要表現有臍周腹痛、腹脹和腹瀉,糞便呈糊狀或水樣,當發生消化或吸收障礙時,則含消化不完全的食物成分,可伴有全身性營養缺乏的表現。常見病種有急性腸炎、腸結核、急性出血性壞死性腸炎、克羅恩病、吸收不良綜合徵、腸梗阻等。
(四)結腸疾病:主要症狀有下腹部一側或雙側疼痛,腹瀉或便秘,粘液、膿、血便,累及直腸時有里急後重。常見病種有痢疾和各種結腸炎、闌尾炎、腸易激綜合徵、潰瘍性結腸炎、結腸癌、直腸癌等。
 肝臟
肝臟(六)膽道疾病:主要臨床表現有右上腹疼痛(膽絞痛)和黃疸。常見病種有膽石症、膽囊炎、膽管炎、膽道蛔蟲症等。
(七)胰腺疾病:主要臨床表現有上腹部疼痛(可向腰背部放射)和胰腺分泌障礙所引起小腸吸收不良和代謝紊亂。常見病種有急、慢性胰腺炎和胰腺癌。
(八)腹膜、腸系膜疾病:腹膜與消化器官有緊密的關係。髒層腹膜形成一些消化器官的漿膜層。腹膜疾病的主要表現為腹痛與壓痛、腹部抵抗感的腹水等。常見病種有各種急、慢性腹膜炎、腸系膜淋巴結結核,腹膜轉移癌等。
診斷
 疾病的診斷
疾病的診斷(二)症狀:典型的消化系統疾病診斷多有消化系統的症狀。但也有病變在消化系統,而症狀卻是全身性的或屬於其他系統的。
(1)厭食或食欲不振 多見於消化系統疾病的胃癌、肝癌、胰腺癌、肝硬化、慢性胃炎等。也可見於其他系統疾病,如肺結核、內分泌疾病等。
(2)噁心與嘔吐 二者可單獨發生,但多相繼出現。見於胃炎、胃癌、幽門痙攣、幽門梗阻、腸梗阻等。
(3)噯氣 是進入胃內的空氣過多自口腔溢出的表現,頻繁噯氣為功能性改變,神經、精神因素所致,也可由胃、十二指腸、膽道等疾病引起。
(4)反酸 是由於胃酸分泌過盛或賁門功能不全,胃逆蠕動致胃酸反流至口的表現,常見於胃、十二指腸疾病。
(5)咽下困難 常見於咽、食管及食管周圍器官、賁門部疾病,如反流性食管炎、食管癌、賁門癌、主動脈及縱隔腫瘤、賁門失弛緩症等。
(6)上腹或胸骨後燒灼感 主要有炎症、化學物刺激食管黏膜或食管神經肌肉活動異常引起的。常見於反流性食管炎、食管潰瘍、胃及十二指腸潰瘍、功能性消化不良等。
(7)腹脹 其原因可為胃腸積氣、積食、積糞、腹水、腹塊、胃腸功能失調等。
(8)腹痛 是常見而複雜的症狀,有時診斷困難,是由多種原因引起,多由於消化器官的膨脹、肌肉痙攣、腹膜刺激、血液供應異常等基本原因所致。
(9)腹瀉 是由於腸蠕動加速,腸分泌增多和吸收障礙所致。
(10)里急後重 是直腸疾病的表現。
(11)便秘 多為結腸平滑肌、腹肌、膈肌、提肛肌張力減低、腸梗阻、直腸反射減弱或消失、結腸痙攣等所致。
(12)嘔血、黑便和便血 嘔血、黑便為上消化道出血,即食管、胃、十二指腸、膽道系統、胰腺疾病所致。便血多為下消化道出血,即小腸、結腸疾病所致。
(13)黃疸 原因複雜,常分類為肝細胞性黃疸、阻塞性黃疸、溶血性黃疸三種,需進行鑑別。
(三)體格檢查:全面系統的體格檢查非常重要,腹部檢查對消化系統的診斷尤為重要。
(四)輔助檢查:
(1)化驗檢查:包括血、尿、便的檢查,其中糞便檢查對胃腸道疾病是一種簡便易行的診斷手段,對腸道感染、寄生蟲病、腹瀉、便秘和消化道出血尤其重要。
 胃十二指腸造影
胃十二指腸造影(3)胃腸動力學檢查,食管腔pH、壓力測定和食管動力測定:此類檢查對診斷反流性食管炎、食管運動障礙性疾病,如食管賁門失弛緩症等有幫助。
(4)脫落細胞檢查:有助於癌瘤的診斷,對食管癌的胃癌的確診率較高。
(5)活組織檢查:肝穿刺活組織檢查是確診慢性肝病最有價值的方法之一。還可通過外科手術進行活組織檢查。這是診斷消化系統器質性疾病的重要方法。
(6)內鏡檢查:可以直接觀察消化道腔內病變和拍照、錄像記錄,並可採取活組織進行病理檢查。
(7)超聲顯像:可顯示肝、脾、膽囊的大小和輪廓,對肝病特別是肝癌、肝膿腫的診斷幫助較大,對腹水和腹腔內實質性腫塊的診斷也有一定價值。
(8)放射性核素檢查:對肝癌和其他占位性病變的定位診斷有一定的價值。
(9)磁共振成像(MRI)
(10)仿真內鏡檢查術
(11)內鏡超聲顯像
(12)膠囊內鏡
防治原則
 疾病防治
疾病防治